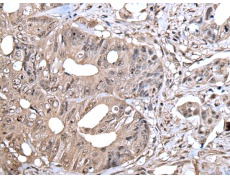
一抗

中文名稱: 兔抗ZYX多克隆抗體
|
Background: |
Focal adhesions are actin-rich structures that enable cells to adhere to the extracellular matrix and at which protein complexes involved in signal transduction assemble. Zyxin is a zinc-binding phosphoprotein that concentrates at focal adhesions and along the actin cytoskeleton. Zyxin has an N-terminal proline-rich domain and three LIM domains in its C-terminal half. The proline-rich domain may interact with SH3 domains of proteins involved in signal transduction pathways while the LIM domains are likely involved in protein-protein binding. Zyxin may function as a messenger in the signal transduction pathway that mediates adhesion-stimulated changes in gene expression and may modulate the cytoskeletal organization of actin bundles. Alternative splicing results in multiple transcript variants that encode the same isoform. |
|
Applications: |
ELISA, WB, IHC |
|
Name of antibody: |
ZYX |
|
Immunogen: |
Fusion protein of human ZYX |
|
Full name: |
zyxin |
|
Synonyms: |
ESP-2; HED-2 |
|
SwissProt: |
Q15942 |
|
ELISA Recommended dilution: |
5000-10000 |
|
IHC positive control: |
Human colorectal cancer |
|
IHC Recommend dilution: |
25-100 |
|
WB Predicted band size: |
61 kDa |
|
WB Positive control: |
293T cell lysate |
|
WB Recommended dilution: |
200-1000 |


 購(gòu)物車
購(gòu)物車 幫助
幫助
 021-54845833/15800441009
021-54845833/15800441009